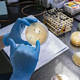

Bomo v Sloveniji kmalu dobili nov državni praznik?

To bi lahko po prizadevanjih predsednice državnega zbora postal dan znanosti. Predsednica državnega zbora Urška Klakočar Zupančič je danes sprejela predsednika Slovenske akademije znanosti in umetnosti (SAZU) Petra Štiha in …
![]() Maribor24 · 2L
Maribor24 · 2L
Se obeta nov državni praznik? Bo dela prost dan?

Predsednica državnega zbora Urška Klakočar Zupančič je danes sprejela predsednika Slovenske akademije znanosti in umetnosti (SAZU) Petra Štiha in člana SAZU Franca Forstneriča. Predsednici sta v pogovoru med drugim predstavila …
![]() Svet24 · 2L
Svet24 · 2L
SAZU: Dan znanosti bi lahko bil državni praznik
Predsednica državnega zbora Urška Klakočar Zupančič je danes sprejela predsednika Slovenske akademije znanosti in umetnosti (SAZU) Petra Štiha in člana SAZU Franca Forstneriča. Predsednici sta v pogovoru med drugim predstavila …
Dnevnik · 2L
urška klakočar zupančičdržavni praznikdan znanostisazuznanost
Klakočar Zupančičeva o predlogu za nov državni praznik

Predsednica državnega zbora Urška Klakočar Zupančič je sprejela predsednika Slovenske akademije znanosti in umetnosti (SAZU) Petra Štiha in člana SAZU Franca Forstneriča. Predsednici sta v pogovoru med drugim predstavila tudi …
![]() 24ur · 2L
24ur · 2L
Se nam obeta nov državni praznik?

Predsednica državnega zbora Urška Klakočar Zupančič je danes sprejela predsednika Slovenske akademije znanosti in umetnosti (SAZU) Petra Štiha in člana SAZU Franca Forstneriča. Predsednici sta v pogovoru med drugim predstavila …
![]() Siol.net · 2L
Siol.net · 2L
državni zborslovenska akademija znanosti in umetnostipraznikznanost
Z obiskom in uporabo spletnega mesta soglašate s piškotki.